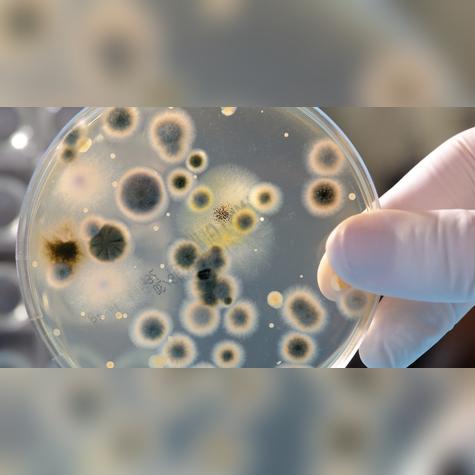
Estos parches eliminar las bacterias de los alimentos. Estos parches eliminar las bacterias de los alimentos.

Científicos crean un parche con virus para eliminar las bacterias de los alimentos
Este innovador invento ayudará a combatir los microorganismos que se albergan en una numerosa variedad de alimentos.


Cada año, miles de personas se enferman al ingerir alimentos contaminados, cuyos microorganismos como Escherichia coli y Salmonella, que se albergan en su interior, son complicados de eliminar con un simple lavado con agua y otros ingredientes. Por ello, un grupo de científicos Canadienses elaboró un parche de microagujas con la capacidad de movilizar un virus al interior de los productos para que destruyan las bacterias y evitar intoxicaciones alimentarias.
Parches con virus para eliminar las bacterias de los alimentos
Estos parches de microagujas, introducen bacteriófagos al interior de los alimentos para eliminar los agentes patógenos que muchos ingredientes caseros y productos no logran llegar, y que si son ingeridos puede ocasionar graves daños de salud e incluso la muerte.
La primera prueba de este revolucionario invento se hizo a una carne de res cruda y pollo cocido contaminados a propósito con las bacterias Escherichia coli y Salmonella. Los resultados revelaron que los bacteriófagos ingresaron en los alimentos y eliminaron hasta un 99,9% de las bacterias, logrando resultados que cumplen con los requisitos establecidos para la seguridad alimentaria actual.
El increíble potencial de los parches: más allá de la eliminación de bacterias
La tecnología del parche permite combinar diferentes virus en uno solo para combatir diversas bacterias a la vez. Lo mejor es que no modifica el aspecto ni el sabor de los alimentos. A pesar de los grandes avances, los científicos siguen trabajando para perfeccionar la tecnología y poder combatir aún más tipos de bacterias, además de probar su efectividad contra los microorganismos que causan el deterioro de los alimentos.

Eso sí, su implementación a gran escala dependerá de las regulaciones en la industria alimentaria y de más investigaciones que garanticen tanto su seguridad como su efectividad. Aunque todavía faltan pruebas, el impacto que esta tecnología puede tener en la seguridad alimentaria mundial es enorme. Y lo mejor de todo: podría ser un paso importante hacia alimentos más seguros y menos dependientes de antibióticos.
Te puede interesar:















